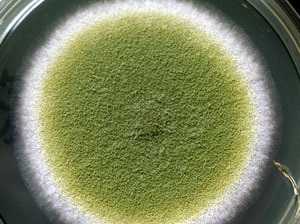

Диагностика микозов - методы исследования, критерии
Добавил пользователь Алексей Ф. Обновлено: 21.01.2026
Медицинская микробиология:
Микологический (культуральный) метод диагностики микозов (грибковой инфекции)
Культуральные методы исследования до сих пор остаются предпочтительными при диагностике микозов. В медицинских микологических лабораториях основной средой для выделения патогенных грибов различных систематических групп является среда Сабуро, жидкая и агаризованная. Для предотвращения роста бактерий в среду добавляют антибиотики — пенициллин и стрептомицин (по 50-100 Ед/мл), либо хлорамфеникол и гентамицин (0,05 г/л), а также циклогексимид (актидион: 0,5 г/л) для сдерживания роста быстрорастущих сапрофитных грибов при изоляции дерматофитов и агентов подкожных микозов.
а) Методы посева патологического материала. После предварительного исследования биосубстратов под микроскопом клинический материал засевают на питательные среды. Посев проводят в стерильном боксе стерильной пастеровской пипеткой, пинцетом, шприцем и т.д. с использованием пламени спиртовки или газовой горелки. При проведении количественных исследований разведенные биосубстраты (мокрота, промывные воды бронхов, гайморовых полостей, моча, кал и пр.) засевают на агар мерно в количестве 0,1 мл. Перед посевом проводят контрольный забор воздуха в боксе на стерильность, чашку инкубируют при 25-30°С.
При проведении исследований на диморфные грибы для выявления психрофильных возбудителей, не растущих при 37°С (Geotrichum candidum, Absidia coerulea), или термотолерантных, слабее растущих при 25-30°С (Rhizopus arrhizus), а также для дифференцированного выделения из патологического материала нескольких видов грибов при смешанных инфекциях, делают парные посевы, так как быстро растущие психрофильные виды при исследовании в одном температурном режиме (25-30°С) могут вытеснять более термотолерантные виды. Посевы проводят в двух емкостях.
1. Кератиновые ткани. В случаях поверхностных микозов используют две среды Сабуро: для выделения дерматофитов — агар Сабуро с циклогексимидом (0,5 г/л) для предотвращения роста сапрофитных грибов и агар Сабуро без циклогексимида, но с гентамицином или хлорамфениколом для выделения не дерматофитных плесневых и дрожжеподобных грибов. Посевы инкубируют в течение 2 недель при температуре 25-30°С.
Соскобы со слизистой полости рта, вагины, уретры засевают на среду Сабуро и инкубируют при 37(’С в течение 7 дней.
Соскобы с роговой оболочки глаз, слизистой носа, отделяемое наружного слухового прохода, поверхностных ран, язв после посева инкубируют на среде Сабуро при 25-30°С. Срок инкубации — 7-10 дней.
2. Кровь засевают в соотношении 1:3 или 1:10 в следующие среды: во флаконы для гемокультур, в бульон Сабуро (среда накопления) или в сердечно-мозговую двухфазную среду. Посевы выращивают в течение 10 дней при температуре 37°С.
При посеве крови в среду накопления (жидкая среда Сабуро) на второй, пятый и седьмой день делают контрольный высев осадка на чашки с агаром Сабуро, которые выдерживаю т в термостате 2-5 суток при температуре 25-30°С и 37°С.
Использование двухфазной среды значительно увеличивает процент выявления грибов и сокращает время инкубации. При посеве крови в двухфазную среду необходимо смачивать поверхность агара засеянным бульоном дважды в день в течение 2 дней и один раз в день — последующие 5 дней. Контрольные высевы не производятся.
3. Спинномозговая жидкость (ликвор). Осадок ликвора засевают на две чашки с агаром Сабуро по 0,1 мл, а остаток спинномозговой жидкости — в пробирки с жидкой средой Сабуро. Чашки инкубируют при 25-30°С и 37°С, жидкую среду — при 25-30"С. Срок инкубации — 10 дней. Посевы начинают просматривать со второго дня. Если на 5-й день рост не обнаружен, производят высев из жидкой питательной среды на чашки с агаром Сабуро. Повторный посев также инкубируют при двух температурах.
4. Жидкости тела. Мокроту, промывные воды бронхов, гайморовых полостей, мочу, сок простаты, желчь, дуоденальный сок, абдоминальную, синовиальную жидкости и др. после предварительной обработки засевают в количестве 0,1 мл на агар Сабуро и инкубируют при 25-30"С и 37°С в течение 7-10 дней.
5. Гной. Материал засевают на агар Сабуро и/или сердечно-мозговой агар, инкубируют при 25-30°С и 37°С в течение 7-10 дней, а в случаях мицетомы — до 4 недель.
6. Ткани. Небольшие фрагменты ткани растирают шпателем по поверхности агара Сабуро. Одновременно кусочки ткани помещают в жидкую среду Сабуро. Посевы инкубируют при 25-30°С и 37°С в течение 10-14 дней.
7. Фекалии. Фекалии разводят 1:10 (1,0 г фекалий и 9 мл физиологического раствора или стерильной воды), размешивают, отстаивают 10 мин для осаждения крупных частиц, затем надосадочную жидкость в количестве 0,1 мл засевают на агар Сабуро. Посев инкубируют при 25-30°С и 37°С в течение 7 дней.
б) Культивирование и интерпретация результатов. Засеянные чашки начинают просматривать на второй день после посева с целью обнаружения начала роста возбудителей и дифференциации их от сапрофитов окружающей среды, которые могут контаминировать посевы. Особенно это важно при исследовании биосубстратов на наличие мицелиальных грибов. При обнаружении плесневых колоний отмечают рост культуры в точке посева и отсутствие роста идентичных штаммов в контрольной чашке (проверка микробиологической чистоты воздушной среды в боксе). Рост грибов Candida и Aspergillus можно видеть уже на 2-3-й день. При наличии медленно растущих патогенов время инкубации продлевается с одновременным пересевом на селективные среды для идентификации и предотвращения зарастания культур сапрофитными контаминантами.
При мерном посеве патологического материала проводят количественный учет выросших колоний в колониеобразующих единицах на 1 мл исследуемого биосубстрата (КОЕ/мл) по формуле п=а*b*с, где а — среднее число колоний, b=10 при объеме посевного материала 0,1 мл, с — степень разведения материала (10, 100, 1000). При интерпретации результатов исследования на кандидоз учитывают количественные критерии содержания Candida в биосубстратах. Так, в норме у здорового человека грибы рода Candida могут присутствовать в смывах с гениталий, в содержимом желудка — до 10 2 КОЕ/мл, в мокроте, смывах с полости рта, в носоглоточной слизи — до 10 3 КОЕ/мл, в кале — до 10 4 КОЕ/мл. В стерильных жидкостях организма (крови, ликворе, содержимом желудочков мозга, желчи, синовиальной суставной жидкости, соке простаты, моче и т.д.) грибы должны отсутствовать. Бронхоальвеолярный лаваж от иммуносупрессированных пациентов расценивают как стерильный биосубстрат для всех возбудителей, кроме Candida.
При посевах отделяемого невскрывшихся абсцессов, биоптатов и пр. количественный учет грибов не проводят, диагностическое значение имеет наличие роста возбудителя. Выявление дерматомицетов при исследовании кожи, волос и ногтей почти всегда свидетельствует о наличии микоза. Клиническое значение выделения различных микромицетов из нестерильных в норме биосубстратов: с поверхности кожи, в соскобах со слизистых оболочек, язв и т. п. неодинаково. При оценке результатов анализа учитывают характер роста выявляемых культур (единичный, умеренный, значительный; рост в точках посева, идентичность возбудителя в парных посевах и т. п.), данные предварительного микроскопического исследования патологического материала, наличие характерных клинических проявлений и сопоставление с литературными данными других исследователей.
Помимо основной среды Сабуро, в современных микологических лабораториях широко используются хромогенные среды («CandiSelect 4»,«Candida ID 2 Agar» и пр.) для первичного выделения дрожжевых грибов, которые позволяют визуально выявлять смешанные культуры дрожжевых возбудителей и значительно облегчают идентификацию Candida spp. Наиболее распространенные виды Candida (С. albicans, С. kmsei, С. tropicalis, С. glabrata и др.) на хромогенных средах идентифицируют по специфическому для вида окрашиванию колоний.
В случае отсутствия в лаборатории хромогенных сред и идентификационных тест-систем для определения дрожжевых грибов используют сыворотку крови, картофельный или кукурузный агары (идентификация С. albicans), агар с дигидроксифенилаланином — для определения Cryptococcus neoformans и т.д.
Плесневые грибы при наличии спороношения можно идентифицировать на среде Сабуро. Но если позволяют время и возможности, грибы пересевают на селективные среды, на которых грибы образуют типичные для своего вида колонии, стимулирующие образование конидий или других характерных структур, важных для определения возбудителя. С целью идентификации видов аспергиллов, пенициллов и других плесневых возбудителей используют агар Чапека, картофельный, кукурузный и дугие агары. Для выявления дрожжевой фазы диморфных грибов применяется сердечно-мозговой агар. Кукурузный агар с сахарозой и дрожжевым экстрактом подходит для спорообразования у некоторых зигомицетов и т.д. Для выполнения посевов разработаны также коммерческие стандартные среды.
Идентификацию выделенных культур производят, прежде всего по морфологическим признакам колоний (по цвету, размеру, структуре, характеру поверхности, пигментации, наличию экссудата и пр.), по микроморфологии гриба (по наличию перегородок в мицелии, псевдомицелия, почкующихся клеток, артроспор, строению конидиеносцев, расположению и форме конидий и т.д.) и биохимическим особенностям (ферментативной и ассимиляционной активности). Микроморфологию гриба изучают в нативных препаратах с добавлением смеси равных объемов спирта, воды и глицерина.
в) Определение чувствительности выделенных культур грибов к антимикотическим препаратам. При диагностике микозов, вызванных дрожжевыми грибами, помимо видовой идентификации возбудителя нужно проводить определение чувствительности к антимикотикам. При невозможности таких исследований в лечении можно использовать имеющиеся в литературе сведения об устойчивости выделенного вида к определенным препаратам. Но часто этого недостаточно, так как даже хорошо изученная и описанная лекарственная чувствительность у ряда видов Candida значительно варьирует у разных штаммов этого вида. У внутрибольничных патогенов возможно развитие резистентности к постоянно применяемым в стационаре ранее эффективным антимикотикам, и простое определение вида возбудителя теряет клиническое значение без последующего проведения теста на чувствительность.
Для определениия чувствительности дрожжевых грибов к антимикотикам применяют стандартизованный метод микроразведений в среде RPMI 1640, используемой в коммерческих тест-системах (например, «Fungitest», Bio-Rad).
Выбор антимикотиков для лечения плесневых микозов представляет определенные трудности, так как стандартизированный метод серийных разведений для плесневых грибов еще не разработан в полном объеме. Можно проводить определение чувствительности диско-диффузионным методом. Но результаты, полученные in vitro, могут не соответствовать эффективности проведенной терапии. На данном этапе установлены минимальные подавляющие концентрации современных антимикотиков (амфотерицин В, флуконазол, итраконазол, кетоконазол, вориконазол) в отношении основных возбудителей плесневых микозов, с учетом которых проводят эмпирическую терапию, одновременно руководствуясь опубликованным опытом других клиницистов.
Диагностика грибковых заболеваний
Грибковые заболевания характеризуются тем, что на ранних этапах выявить поражение практически невозможно без специальной диагностики. Симптомы первоначального развития смазаны, и только по мере прогрессирования поражения они начинают проявляться.
Грибковые заболевания, или микозы, представляют собой патологии, возникающие в результате поражения паразитами внутренних органов, кожи, ногтей. Возбудитель заболевания - грибковые бактерии, среди которых можно выделить следующие:
- грибок Кандида (Candida) - вызывает кандидозные инфекции;
- Трихофитии (Trichophyton) - провоцирует инфекционные патологии ногтей, кожи, слизистых оболочек;
- Криптококкоз - атакует внутренние органы, легкие;
- Аспергиллез - грибковое заболевание, вызванное снижением иммунитета.
Виды и классификация микоза
Диагностика грибка в медицинском центре Ейска «Сенситив» нацелена на определение одной из 2 групп инфекции в зависимости от ее локализации:
- Поверхностное поражение кожи, слизистых, при этом не происходит распространение на внутренние органы. Обычно вызывается грибками рода трихофитии, кандида.
- Системное поражение внутренних органов, диссеминации паразитов с кровью. Вызывается грибками рода аспергиллез, криптококкоз.
Возбудитель проникает через ранки на поверхности кожи, микротравмы, при этом достаточно одной царапины, и при попадании в нее грибка, будет развиваться микоз гладкой кожи. Особенно быстро заражаются при снижении защитных функций. Чаще всего человек заражается родом трихофитон или Кандида. В свою очередь грибок Кандида вызывает такие заболевания:
- молочница;
- кандидоз у мужчин;
- кандидоз ротовой полости.
По методу поражения тканей выявляют более нескольких десятков возбудителей, которые можно разделить на следующие виды:
- глубокие системные микозы провоцирует Histoplasma capsulatum;
- субкутанные подкожные микозы вызывает Sportrichum schenckii;
- эпидермомикозы развиваются из-за Epidermophyton floccosum;
- отрубевидный лишай, поверхностный микоз — Malassezia furfur;
- оппортунистические грибковые заболевания — Candida albicans.
Как диагностировать грибок
Если врач дерматолог ставит предварительный диагноз «микоз», то пациент обязательно направляется на диагностику. Лечение заболевания будет зависеть от того, какой именно возбудитель послужил началом его развития, и для этого исследованию подвергаются биологические материалы пациента.
В медицинском центре Ейска «Сенситив» для диагностики грибковых заболеваний применяют следующие методы:
- микроскопия - исследование под микроскопом биоматериала;
- исследование под лампой Вуда, которая имеет специальный спектр ультрафиолетового освещения, помогающего заметить грибковые поражения;
- бактериологический посев - точный, но наиболее длительный способ диагностики;
- ПЦР-диагностика - самый точный способ определения вида патогенной микрофлоры в нескольких модификациях.
Самый эффективный и информативный метод — лабораторная диагностика грибковых заболеваний:
- бактериологический посев;
- гистологический анализ;
- ПЦР-диагностирование;
- иммунологическое исследование;
- микробиологические исследования;
- культкуральное исследование.
Микробиологическая диагностика микозов - это метод, для которого необходимо собрать материал для исследования: пораженные волосы, а с кожи сделать соскоб поврежденного участка. Биоматериалы помещаются в раствор гидроксида калия 30%, потом на предметное стекло. Это позволяет выявить локализацию грибка и размеры поражения. Используют для диагностики следующие методы микробиологической диагностики:
- микроскопия с нативными и неокрашенными препаратами;
- микроскопия с окрашенными препаратами.
Сдать анализ на грибок вы можете в медицинском центре Ейска «Сенситив» в любой день.
Диагностики микоза
Микоз - заболевание, вызванное патогенными или условно-патогенными грибками. Обычно возникает на фоне иммунодефицита. Может поражать как внешние покровы тела, так и внутренние органы.
Существует несколько методов диагностики микоза. Некоторые из них могут применяться не только для постановки диагноза, но и с целью определения чувствительности возбудителя к антимикотикам. Выбор метода обследования осуществляет врач-дерматолог. Он ориентируется на предполагаемую локализацию патологического очага и анатомическую доступность необходимой зоны. Чтобы обнаружить и подтвердить наличие микоза, используются визуальный осмотр, микробиологические, серологические, молекулярные или лучевые способы обследования.
Виды диагностики микоза
Показан при диагностике грибковых процессов, локализованных на поверхности кожи. Для выявления микоза открытых участков тела порой хватает осмотра невооруженным глазом. При наличии очагов болезни на волосистой части головы используется лампа Вуда. Последняя представляет собой источник ультрафиолетового свечения с длиной волны менее 400 нм. Позволяет выявить характерные признаки грибкового поражения кожи, в т. ч. микрошелушение.
Для подтверждения данных, полученных при осмотре, нужна микроскопия - исследование соскоба пораженной зоны под микроскопом. Для приготовления препарата используются слущенные частицы кожи, мелкие кусочки ногтей, волосы. Изучение биоматериала позволяет увидеть споры и мицелий, установить факт грибковой природы болезни. Выявить разновидность возбудителя удается не во всех случаях. Важное условие точности микроскопического осмотра - отмена противогрибковых лекарств за 10 дней до забора пробы.
Считается основным способом выявления внутренних микозов, однако может использоваться и для диагностики грибка кожи. Суть метода заключается в посеве биосубстрата на питательную среду. Это позволяет увеличить колонию возбудителя в несколько раз, подтвердить факт его наличия, установить вид и чувствительность патогена к тому или иному лекарственному средству. Главный недостаток микробиологического способа - его длительность. Тестирование может занимать от 2-3 дней до 8 недель.
В качестве биологического субстрата используются кровь, моча, ликвор, бронхоальвеолярный лаваж и другие биологические жидкости. Важно, чтобы за 7-10 суток до взятия биоматериала пациент прекратил прием антимикотиков. В противном случае высока вероятность ложноотрицательного результата исследований. Способ подходит для выявления всех грибковых процессов в анатомических зонах, с которых технически возможно получить смывы.
Микробиологические методы занимают много времени, поэтому не могут использоваться для обследования пациентов с острыми формами заболевания. Чтобы ускорить диагностику, применяются серологические способы выявления возбудителя. Они прекрасно подходят для выявления инвазивных микозов на ранних этапах развития, не требуют проведения травмирующих манипуляций для забора биосубстрата, обладают высокой точностью. К сожалению, специфические серологические тесты разработаны только для инвазивного аспергиллеза, криптококкоза, некоторых эндемичных грибковых инвазий.
В основе серологической диагностики грибковых заболеваний лежит обнаружение в крови специфических антител, которые продуцируются иммунной системой в ответ на проникновение той или иной разновидности возбудителя. Точность метода может быть снижена у пациентов, страдающих СПИДом. Их организм практически полностью теряет способность синтезировать антитела. Чувствительность возбудителя к лекарствам с помощью серологических тестов не определяется.
На сегодняшний день продолжается изучение возможности использовать молекулярные методы диагностики для выявления грибковых заболеваний. Разработаны праймеры к различным возбудителям, появилась возможность использовать в качестве биосубстрата не только кровь, но и другие биологические жидкости. Тест позволяет как подтвердить наличие патогенной флоры фактически, так и определить ее точное количество в очаге. Анализ занимает 1-3 дня, в зависимости от загруженности лаборатории и используемого оборудования.
В основе молекулярных диагностических тестов лежит многократное увеличение сверхмалых фрагментов ДНК исследуемого микроорганизма в ходе полимеразной цепной реакции. Основной недостаток ПЦР-тестов - узкая специфичность. Чтобы назначить это исследование, врач должен точно знать, на наличие какой разновидности грибковой флоры он хочет проверить пациента.
Запись на диагностику микоза
Раннее выявление грибковых заболеваний даст Вам возможность избавиться от патологии в короткие сроки и не допустить осложнений.
Узнать подробности проведения процедуры, цены диагностики микоза и записаться на консультацию специалиста Вы можете по телефону:
Лабораторная диагностика микозов

Микозы - инфекции, вызываемые микроскопическими грибами, подразделяют на глубокие, подкожные и поверхностные. Первые два типа встречаются относительно редко, в то время как поверхностные микозы широко распространены и могут проявиться у любого человека, независимо от возраста.
В настоящее время список потенциальных возбудителей микозов включает уже более 500 видов грибов. Микроскопические грибы (микромицеты) значительно отличаются от других возбудителей инфекций, что влечет за собой особые подходы к диагностике и лечению грибковых инфекций. Для диагностики микозов используют данные клинической картины, микроскопического и культурального исследования (посева на грибы).
Культуральная диагностика микозов основана на выделении возбудителя из исследуемого материала. Сроки культивирования различны для разных видов грибов (от 2-4 дней до 4 недель). Для получения адекватного результата необходимо исключить применение противогрибковых препаратов, местных антисептиков не менее чем за 7-10 дней. Использование косметических средств может исказить результаты исследования, в связи с чем рекомендовано воздержаться от их применения за 2 суток до сдачи биоматериала.
Фарингомикоз
Микотическое поражение слизистой оболочки зева и ротовой полости - фарингомикоз - чаще всего вызывают грибы рода Candida, в частности, Candida albicans. При фарингомикозе отмечают присутствие творожистого белого налета на слизистой оболочке полости рта, часто - ощущение першения или жжения, неприятный запах, иногда - поверхностные изъязвления, эрозии, боль.
Кандидоз полости рта, обусловленный C . А lbicans

Ростовая трубка C . albicans
Отомикоз
Отомикоз - грибковая инфекция уха, которая может поражать структуры наружного и среднего уха. Отомикоз не имеет специфичных симптомов. Он может проявляться зудом, болью, шумом и заложенностью в ухе, снижением слуха по типу кондуктивной тугоухости, истечением выделений из наружного слухового прохода. Возбудителями отомикозов, чаще всего, являются грибы рода Aspergillus.

Колония Aspergillus fumigatus
Вагинальный кандидоз
Вагинальный кандидоз - микоз слизистой оболочки влагалища, возникающий при ее колонизации штаммами дрожжеподобных грибов Candida. В острой стадии отмечаются покраснение, отек и зуд вульвы; болезненность, жжение и зуд во влагалище; обильные, творожистого вида выделения из половых путей; в хронической - сухость и атрофия слизистой оболочки, экскориации, выраженная лихенизация.
Микозы кожи и ее придатков.
Микозы кожи (дерматомикозы) - группа заболеваний, в основе которых лежит инфицирование кожи, ногтей, волос вызываемое болезнетворными грибками. Общими проявлениями служат шелушение, мокнутие, воспалительные явления кожи, наслоение чешуек, сильный зуд, утолщение и изменение структуры кожи, ногтей, волос. При расчесах - присоединение вторичной инфекции и нагноение.

Микоз гладкой кожи. Микроспория.



Трихофития волосистой части головы.

Онихомикозы
Онихомикоз - инфицирование ногтей на ногах и руках представителями различных классов патогенной и условно-патогенной грибковой микробиоты. Клиническая картина онихомикоза зависит от причины, вызвавшей микоз. Поражённые грибком ногти меняют цвет и прозрачность, теряют гладкость, утолщаются, становятся ломкими и шероховатыми, расслаиваются, начинают крошиться. При этом подногтевое и околоногтевое пространство может оставаться неизмененным либо краснеть, отекать и поражаться вторичной патогенной флорой.
Причиной онихомикоза является патогенный или условно-патогенный грибок. Развитие онихомикоза провоцируют травмы, в том числе при маникюре и педикюре, плоскостопие, варикоз, гипергидроз, эндокринные и иммунологические нарушения, заболевания крови, патология сосудов, длительный приём гормональных препаратов, антибиотиков и цитостатиков, ношение тесной обуви и отказ от соблюдения общепринятых норм личной гигиены. Заболевание развивается не сразу, ему предшествует поражение кожных покровов подошв и ладоней, и только потом возбудитель внедряется в ноготь.
На здоровую кожу возбудитель попадает с заражённых предметов быта или при контакте с инфицированным человеком. Затем грибок распространяется по коже при прикосновениях к загрязненным участкам. Колонизация подногтевого пространства грибком приводит к бессимптомному размножению возбудителя, достижению им критической массы и проникновению из-под свободного края ногтевой пластинки в роговые слои ногтя при любом провоцирующем воздействии (например, при травме ногтя или околоногтевых тканей). Попав в ногтевую пластинку, грибок размножается, формируя в ткани ногтя туннели, ходы и каналы. Степень поражения ногтевой пластинки зависит от химической структуры ногтя и от вирулентности грибка.
Грибы в доме человека
Грибы-микромицеты широко распространены в окружающей среде, в том числе внутри жилых помещений. Среди микроскопических грибов, обнаруживаемых в помещениях, можно выделить виды, которые могут обладать 1) патогенными, 2) аллергенными, 3) токсическими, 4) биоразрушающими свойствами.
Патогенные и условно-патогенные грибы способны вызывать грибковые заболевания у людей с пониженным, а в ряде случаев и с нормальным иммунитетом. Аллергенные свойства грибов проявляются при вдыхании спор грибов или употреблении в пищу продуктов, содержащих грибковые метаболиты, и выражаются в виде респираторных и, реже, нереспираторных симптомов. Некоторые вещества, выделяемые грибами, обладают токсическим действием и способны угнетать центральную нервную, а также дыхательную систему.
Биоразрушающее действие грибов, обусловленное их способностью усваивать различные субстраты, в том числе дерево, бетон, полимерные материалы, может представлять серьезную опасность для строительных конструкций, а сами грибы-биодеструкторы - проявлять патогенные, аллергенные и токсические свойства.
Повышенное содержание грибов в помещении может приводить к развитию так называемого «синдрома больного здания», выражающегося в общем ухудшении самочувствия, проявлении различных (острых и хронических) заболеваний, повышении утомляемости, снижении работоспособности и т.д., что особенно неблагоприятно отражается на детях и лицах пожилого возраста. Микологическое обследование помещений позволяет выявить причины, и принять адекватные меры по их устранению, что позволяет существенно улучшить состояние здания, устранить негативное влияние грибов на организм человека.
Грибы как причина аллергических заболеваний
Грибы обладают выраженными аллергенными свойствами. Наиболее часто встречается сенсибилизация к плесневым грибам, проявляющаяся различными респираторными симптомами (кашель, насморк, бронхиальная астма и т.п.) при вдыхании спор грибов. Нереспираторные проявления микогенной аллергии встречаются реже, хотя некоторые виды грибов, поражающие плодоовощную продукцию и зерновые ( Phoma , Fuzarium , Penicillium expansum ,) вносят значительный вклад в общее число аллергии к грибам. Сенсибилизация в таком случае происходит при употреблении в пищу продукции, зараженной грибами (ягод, фруктов, овощей, а также продуктов их переработки). Аллергенные компоненты грибов способны проникать в непораженные части плода без изменения их вкуса и часто сохраняются при кулинарной обработке. Гниль яблок и цитрусовых, темные пятна на свекле и моркови, поражения картофеля и томатов - с такими продуктами людям, склонным к аллергии, нужно быть осторожными. Хлеб, мука, крупы могут сохранять виды грибов, присутствовавших на вегетативных частях растений (фузарии, нейроспора, фитопатогены). Молоко, кефир, творог обычно содержат дрожжеподобные грибы, а пиво, вино, сыры - продукты их жизнедеятельности.
Диагностика микозов - методы исследования, критерии
Иммунологический метод и ПЦР диагностика микозов (грибковой инфекции)
Диагностическая ценность иммунологических тестов возрастает при висцеральных микозах из-за трудности выделения тканевых форм возбудителей. Традиционные микологические методы (микроскопия, посев, гистологическое исследование) нередко недостаточно чувствительны и не всегда специфичны. Они могут потребовать длительного времени, а для получения материала может быть необходимо проведение инвазивных процедур. При диагностике микозов среди различных иммунологических методов исследования наибольшее распространение получили реакция связывания комплемента (РСК), реакция иммунодиффузии (РИД), иммуноэлектрофореза (ИЭФ). С помощью иммунодиагностики можно проводить мониторинг эффективности проводимого лечения по снижению титров антител. Для более точной диагностики рекомендуется параллельно использовать несколько методов.
Однако все серологические методы по определению вида и титра специфических антител в крови имеют ограничения в возможности диагностики заболевания. Так, их специфичность и чувствительность зависят от качества и стандартизации антигенных препаратов. Наличие перекрестных реакций может давать ложноположительный ответ, а в случаях снижения или отсутствия иммунного ответа у иммуносупрессированных пациентов — ложноотрицательный. В данной области чувствительные и специфичные стандартизованные серологические методы разработаны лишь для криптококкоза, инвазивного аспергиллеза и эндемичных микозов (кокцидиоидоз, гистоплазмоз, бластомикоз, паракокцидиоидоз).
В рутинной лабораторной практике наиболее распространены исследования по выявлению в крови антигенов грибов (ИФА или латекс-агглютинация). Быстрый и эффективный метод диагностики криптококкоза — определение полисахаридного антигена капсулы Cryptococcus в ликворе и сыворотке крови («Pastorex Cryptoplus», Bio-Rad) обладает чувствительностью и специфичностью соответственно в 90-95% и 60-70% случаев. Ложноположительные результаты возможны при наличии ревматоидного фактора и при злокачественном новообразовании.
а) Инвазивный аспергиллез диагностируют по наличию антигена галактоманнана в сыворотке крови. Чувствительность и специфичность теста «Platelia Aspergillus» (Bio-Rad) составляет 80 -90 %. Ложноположительные результаты могут вызываться эмпирической антифунгальной терапией, применением некоторых антибактериальных препаратов (пиперациллина), наличием галактоманнана в продуктах питания (крупа, макароны), а также перекрестными реакциями с экзоантигенами бактерий и других грибов. Определение антител не применяют в связи с нарушением их продукции у иммуносупрессированных пациентов. Эти исследования имеют значение для диагностики хронического некротизирующего аспергиллеза и аспергилломы.
б) Инвазивный кандидоз. Существующие методы определения специфических антител характеризуются низкой чувствительностью и специфичностью в связи наличием антител у больных с поверхностной колонизацией желудочно-кишечного тракта, а также нарушением продукции иммуноглобулинов у пациентов с иммуносупрессией. Выявление антигена маннана — компонента клеточной стенки Candida затруднено в связи с коротким временем выведения из кровотока и связыванием с антиманнановыми антителами. Чувствительность и специфичность имеющихся тестов для определения маннана не превышают 50%.
в) Молекулярные методы исследования патологического материала. В настоящее время широко и интенсивно изучается возможность применения ПЦР в диагностике микозов. В качестве исследуемого материала берут кровь, возможно использование мочи, слюны или ногтевых пластинок при выявлении дерматофитов. Разработаны праймеры к разным возбудителям. Диагностическая чувствительность, специфичность и скорость проведения реакции зачастую превосходят таковые при культуральном и серологических методах исследовании патологического материала. Однако ПЦР не может полностью заменить другие методы исследования, так как разработанные тест-системы не охватывают весь спектр условно-патогенных возбудителей. Кроме того, при работе этим методом возникает ряд проблем: ложноположительные результаты из-за контаминации образцов, сверхчувствительности этой реакции, а также из-за наличия ингибиторов ПЦР в образце и др.
Реже применяется газожидкостная хроматография, выявляющая некоторые компоненты клеточной стенки гриба в крови. Хроматография, как правило, ограничивается диагнозом кандидозов.
Читайте также:
- Наследование групп крови. Определение группы крови.
- Динамика рака гортани в рентгеновском изображении. Дифференциальная диагностика опухолей гипофаринкса и гортани
- Флюоресцентная ангиография меланомы хориоидеи c неоваскулярной хориоидальной мембраной
- Что за болезнь корь, симптомы, лечение, вирус кори
- Общий осмотр в неврологии. Форма черепа
